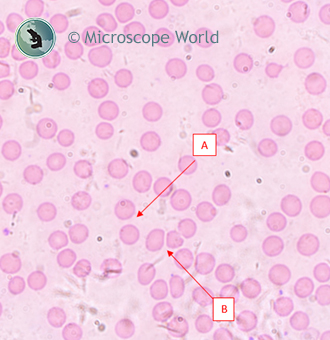
Blood cells under the microscope

Microscope Resolution Explained Using Blood Cells
Mar 7th 2019
Quite often people tell us the microscope resolution they need, but they don't really know what they mean by resolution. That's okay, as it is not necessarily a straight-forward concept.
What is Resolution In A Microscope?
In microscopy, resolution is a numeric quantification of how clearly an objective lens can image a specimen. More specifically, it is the shortest distance between two objects within a specimen at which the two objects can be distinguished from each other. Resolution is a calculated number, inversely related to the Numeric Aperture (NA) of the lens. Therefore, the higher the objective lens NA, the smaller the resolution. But don't let that mislead you; a smaller resolution number is a good thing! It means that specific lens can more clearly show smaller and smaller samples.
Microscope Resolution Equation
There are a few different equations that allow us to state what an objective lens' resolution is, and show the relationship between resolution and NA. Here is one equation we use: (r) = 0.61λ / NA, where r is resolution, λ is the imaging wavelength (550nm on average), and NA is the numeric aperture of the objective lens in question. So, if a 10x objective lens has a NA of 0.25, the resolution of that lens is (0.61 x 550nm) / 0.25, or 1.34µm. For a 100x objective lens with a NA of 1.25, the resolution of that lens is (0.61 x 550nm) / 1.25, or 0.268µm.
That is a lot of math! What does it all mean in practical terms?
Understanding Microscope Resolution
This is a picture of stained blood cells viewed with a 10x objective lens under the RB20 microscope, taken with a 5mp microscope camera.

The blood cells are between 6µm and 10µm in diameter. You certainly can see them, and can generally make out individual cells, but it is very hard to discern the space between the cells that are closely clumped together.
To get a better idea of our resolution, we zoomed in on the center of the image digitally to about 10x.

The space between the cells bordering the end of line A is about 2µm. This gap can be seen clearly with the 10x lens. The space between the cells bordering line B (there is a space there) is about 0.6µm. This second gap can not be seen with the 10x lens. This is consistent with the lens' resolution, which is 1.34µm (as we calculated above).
Here is an image of the same slide taken with the same microscope and camera, but using the 100x objective lens. Obviously, the image is much larger and much clearer than with the 10x lens. The improved resolution with the 100x lens can be quantified by looking at the same two points on the slide. The edges of gap A are much more defined, and gap B, which can't be seen with the 10x lens, can easily be seen with the 100x lens. Again, this makes sense given the NA we calculated of 0.268µm.
Here is an image of the same slide taken with the same microscope and camera, but using the 100x objective lens. Obviously, the image is much larger and much clearer than with the 10x lens. The improved resolution with the 100x lens can be quantified by looking at the same two points on the slide. The edges of gap A are much more defined, and gap B, which can't be seen with the 10x lens, can easily be seen with the 100x lens. Again, this makes sense given the NA we calculated of 0.268µm.
If you have any questions about resolution, what kind of lenses you need, or what type of microscope best suits your needs, feel free to contact Microscope World. We are fascinated by this type of stuff.





